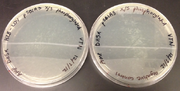
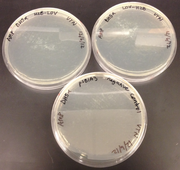
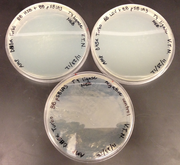
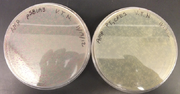

Uploads by Vi Nguyen
From OpenWetWare
Jump to navigationJump to search
This special page shows all uploaded files.
| Date | Name | Thumbnail | Size | Description |
|---|---|---|---|---|
| 14:08, 7 May 2013 | VN Mutagenesis Transformation Trial 2 DH5a.png (file) |  |
405 KB | |
| 14:00, 7 May 2013 | VN Mutagenesis Transformation Trial 1 BL21.png (file) |  |
557 KB | |
| 12:51, 18 April 2013 | VN Gel 2-8-13.png (file) |  |
34 KB | |
| 12:43, 18 April 2013 | VN Gibson Assembly Trial 2.png (file) | |
361 KB | |
| 12:33, 18 April 2013 | VN Gibson Assembly Trial 1.png (file) | |
390 KB | |
| 14:18, 8 December 2012 | VN H2B and LOV Transformation Trial 2.png (file) | |
448 KB | |
| 14:14, 8 December 2012 | VN Gel 12-6-12.png (file) |  |
165 KB | |
| 13:36, 8 December 2012 | VN Gel 11-23-12.png (file) |  |
319 KB | |
| 13:12, 22 November 2012 | VN Gel 11-21-12.png (file) |  |
137 KB | |
| 13:00, 22 November 2012 | VN H2B and LOV Transformation Trial 1.png (file) |  |
402 KB | |
| 19:58, 21 November 2012 | VN Vector Cultures.png (file) | |
453 KB | |
| 19:56, 21 November 2012 | VN Gel 11-20-12.png (file) |  |
181 KB | |
| 11:57, 14 November 2012 | VN Gel 11-14-12.png (file) |  |
194 KB | |
| 12:22, 12 November 2012 | Gel 11-9-12.png (file) |  |
100 KB | |
| 19:17, 9 November 2012 | VN Gel 11-7-12.png (file) |  |
139 KB | |
| 14:46, 7 November 2012 | VN Gel 11-6-12.png (file) |  |
258 KB | |
| 14:15, 7 November 2012 | VN Plate Cultures.png (file) |  |
431 KB | |
| 13:58, 7 November 2012 | Plate Cultures.JPG (file) |  |
2.37 MB |